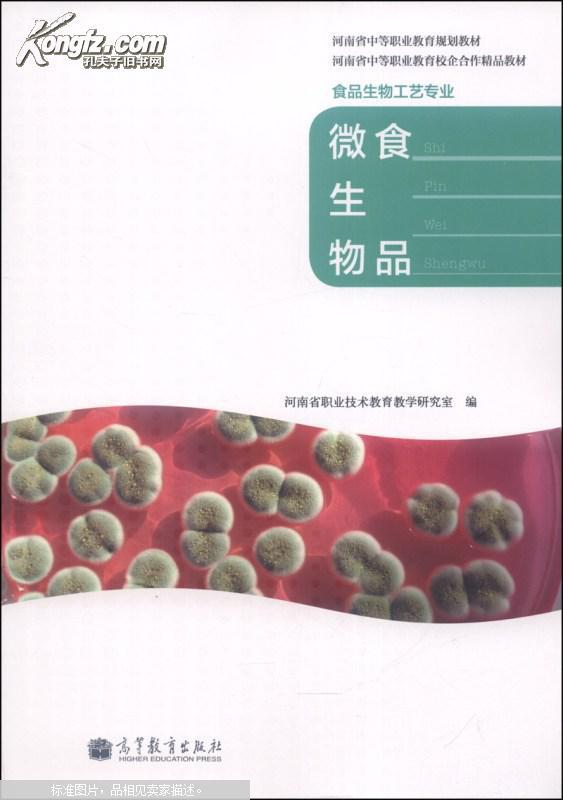
【图】食品微生物\/河南省中等职业教育规划教

河南省中等职业技术教育规划教材:畜禽营养与
240x300 - 8KB - JPEG

河南教育厅的学历认证中心做个学历认证需多长
400x266 - 14KB - JPEG

【专业定制陕西省中等职业教育认证报告】价格
1690x1268 - 261KB - JPEG

河南旅游(旅游服务与管理专业河南省中等职业
617x868 - 91KB - JPEG

河南省中等职业教育规划教材:畜禽生产技术(畜
240x300 - 7KB - JPEG

【河南省中等职业教育规划教材 河南省中等职
800x800 - 46KB - JPEG
【图】食品微生物\/河南省中等职业教育规划教
563x800 - 39KB - JPEG

【机械设备控制技术(河南省中等职业教育规划
800x800 - 86KB - JPEG

河南省中等职业技术教育规划教材任务引领系列
420x420 - 23KB - JPEG

河南省中等职业技术教育规划教材:现代农艺基
701x347 - 39KB - JPEG

【河南省中等职业教育规划教材 河南省中等职
800x800 - 34KB - JPEG

【汽车电气设备与维修\/河南省中等职业教育规
800x800 - 28KB - JPEG

【汽车美容与装潢\/河南省中等职业教育规划教
800x800 - 22KB - JPEG

河南省中等职业技术教育规划教材旅游服务与管
420x420 - 22KB - JPEG

【河南省中等职业技术教育规划教材:旅游英语
800x800 - 38KB - JPEG
为进一步加强中等职业教育学历证书认证管理工作,方便群众办理中等职业教育学历认证,自2017年12月18日起,省教育厅对河南省中等职业教育学历
为加快推进我省中等职业教育信息化建设,提升全省中等职业教育信息化基础水平和信息技术应用水平,省教育厅、省财政厅决定2017-2018年实施河南
根据《河南省教育厅关于申报2018年度河南省中等职业教育专业技能名师工作室的通知》(教职成〔2018〕626号)精神,经市(县)教育行政部门、各学
根据河南省教育厅《关于开展河南省中等职业教育竞赛系列活动的通知》(教职成[2018]37号)精神,2018年全省中等职业教育技能大赛全员化试点项目
河南省教育厅颁发的普通中专毕业证书、普通中师毕业证书、成人中专毕业证书、职业中专毕业证书、职业高中毕业证书,其他特殊情况经研究需要
中等职业教育学历证书认证工作坚持“谁发证谁认证、谁审核谁负责”的基本原则。由省教育厅和原河南省教育委员会验印的中等职业教育毕业证
以河南省中等职业教育管理强校评选为抓手,进一步推动我省中等职业学校完善管理制度、规范办学行为、增强办学活力、提升办学质量、建立多元
国家级重点中专、省职业教育先进单位 王志电──河南省信绝不放弃每一个学生,为每一个学生 技能大赛更多 2017年全省中等职业教育技能大赛开 教育厅文件 职教室文件 成
2.认证方法:申请人登陆河南省职业教育与成人教育网(),在线注册、上传认证所需材料的 (1)学习形式,中等专业学校、师范学校、卫生学校等录取的是初中或高中毕业生,即使毕
三、申请所需材料 1.毕业证书原件及复印件1份(毕业证书原件丢失的,请提供毕业学校出具的有关证明); 2.身份证复印件1份; 3.填写河南省中等职业教育学历认证申请表; 4.2007